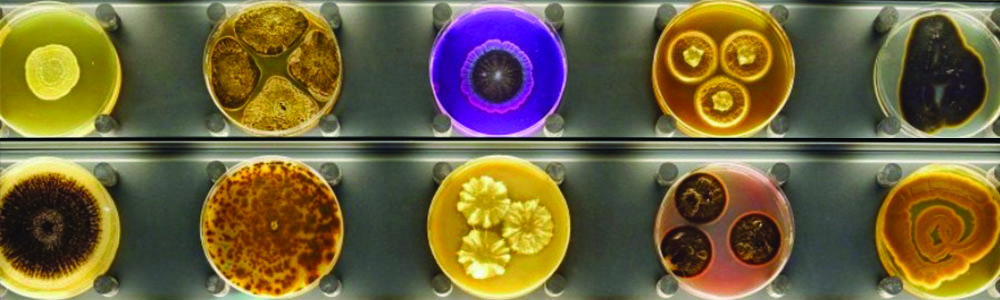

At its core, design is storytelling: arranging semantic languages to guide users through interactions that resolve into meaning, and orchestrate emotion. All information is more relatable, persuasive, memorable, and motivating when it is organized into a familiar story structure. By applying story structure to design – how we identify as makers, develop and present ideas, sequence processes, products, and experiences – students will learn how to leverage storytelling to attract people to their work, vision, and journey.
- Instructor: Jeremy Mende
- Instructor: Saraleah Fordyce
- Instructor: Sudhu Tewari

- Instructor: Scott Thorpe